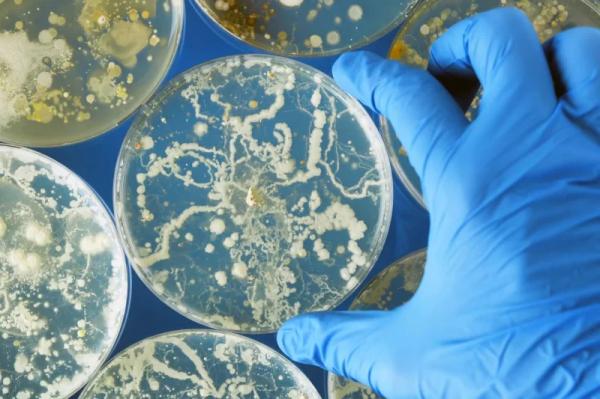

Deadly fungal illnesses linked to Medical tourism in Mexico
An outbreak of Fusarium solani meningitis occurred at two clinics specializing in elective cosmetic procedures like breast augmentation, liposuction and Brazilian butt lifts. Photo by Adobe Stock/HealthDay News
Medical tourism to Mexico for cosmetic procedures exposed Americans to a deadly fungal infection last year, a new report shows.
An outbreak of Fusarium solani meningitis occurred at two clinics in Matamoros specializing in elective cosmetic procedures like breast augmentation, liposuction and Brazilian butt lifts. Advertisement
The new report, published Thursday in the New England Journal of Medicine, tracked the progress of 13 hospitalized patients exposed to the F. solani fungus through epidural anesthesia administered by the River Side Surgical Center and Clinica K-3 between Jan. 1 and May 13, 2023.
Nine of the 13 patients died from injury to arteries feeding their brainstem, brain and spinal cord, said lead researcher Dr. Nora Strong, a postdoctoral fellow in infectious diseases at the University of Texas Health Science Center in Houston.
“The outbreak of this severe mold infection affected primarily young, otherwise healthy people as result of medical tourism,” Strong said in a university news release. “Patients from Mexico and the U.S. experienced severe, and ultimately mortal, neurologic and vascular injuries as a result of the infection.”
Epidural anesthesia directly injected F. solani fungus into the patient’s cerebrospinal fluid, which can cause severe meningitis in otherwise healthy people, the report noted. Advertisement
“Over time, multiple patients experienced the narrowing of important blood vessels in their brains, leading to stroke or severe hemorrhages that eventually led to death in many of the patients,” Strong said.
Three of the four surviving patients remain on an experimental antifungal treatment for invasive mold infections, the researchers said.
One patient who remains on therapy has experienced a state of diminished motivation following a bleed into the space surrounding their brain, results show. The other three survivors escaped with no long-term thinking, sensory or motor deficits from their infection.
Nearly all patients were treated with systemic antifungal therapy, which initially improved their condition.
However, this standard therapy eventually failed and rapid fungal regrowth occurred in the patient’s spinal fluid.
“Eventually, we learned through advanced molecular and microbiological techniques that the fungus was resistant to all antifungal agents, except the experimental drug Fosmanogepix,” said senior researcher Dr. Luis Ostrosky-Zeichner, division director of infectious diseases at the University of Texas Health Science Center.
“Using that, along with state-of-the-art neurosurgical and endovascular techniques, changed the course of the outbreak,” Ostrosky-Zeichner added.
The U.S. Centers for Disease Control and Prevention has more about the Mexico outbreak.
